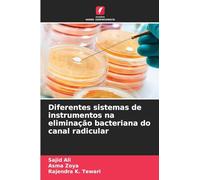
Diferentes sistemas de instrumentos na eliminação bacteriana do canal radicular

Diferentes sistemas do corpo humano
Diferentes sistemas do corpo humano

Valutazione complessiva: 2,5 / 5 (media da diverse fonti di recensioni, aggiornata al 8 apr 2026)
Basata su un totale di 1.468 recensioni dei clienti provenienti da piattaforme indipendenti.
Fonti e trasparenza:
I valori derivano da valutazioni pubbliche di negozi su piattaforme come Feedaty, eKomi, Trustpilot e altre, e vengono aggregati mensilmente.
Tutti i marchi e i loghi sono di proprietà dei rispettivi titolari.
Avvertenza:
prezzo.org non può garantire che le recensioni pubblicate provengano da consumatori che abbiano effettivamente effettuato un acquisto presso il negozio valutato.
Basata su un totale di 1.468 recensioni dei clienti provenienti da piattaforme indipendenti.
Fonti e trasparenza:
I valori derivano da valutazioni pubbliche di negozi su piattaforme come Feedaty, eKomi, Trustpilot e altre, e vengono aggregati mensilmente.
Tutti i marchi e i loghi sono di proprietà dei rispettivi titolari.
Avvertenza:
prezzo.org non può garantire che le recensioni pubblicate provengano da consumatori che abbiano effettivamente effettuato un acquisto presso il negozio valutato.
Prezzo totale più basso
Disponibilità immediata. Disponibile consegna express con Amazon Prime.
Addebito in c/c
Addebito in c/c
Visa
Visa
Mastercard
Mastercard
43,90 €
Spedizione gratuita
Diferentes sistemas do corpo humano

Disponibilità immediata
Addebito in c/c
Addebito in c/c
Visa
Visa
Mastercard
Mastercard
65,45 €
Spedizione gratuita
Diferentes sistemas do corpo humano

Disponibilità immediata
Addebito in c/c
Addebito in c/c
Visa
Visa
Mastercard
Mastercard
83,38 €
Spedizione gratuita
🤖 Chiedi a ChatGPT
💡 Ne vale la pena?
🔁 Ci sono alternative migliori?
⭐ Cosa ne pensano gli utenti?
Diferentes sistemas do corpo humano - Dettagli
▶ Trova sempre il prezzo più conveniente!
Abbiamo trovato 3 prezzi per Diferentes sistemas do corpo humano La nostra lista dei prezzi è sempre trasparente e visualizzata in ordine crescente di prezzo. Possono aggiungersi costi di spedizione.
Diferentes sistemas do corpo humano - Informazioni sul prezzo
- Prezzo più basso: 43,90 €
- Il prezzo più basso è offerto dallo shop Amazon.it. Lì puoi effettuare l'ordine per l'offerto.
- Con un totale di 3 offerte, la variazione di prezzo per Diferentes sistemas do corpo humano oscilla tra 43,90 €€ - 83,38 €€.
- Metodi di pagamento: Amazon.it accetta Addebito in c/c, Visa, Mastercard.
- Consegna: il tempo di consegna più veloci è offerto dallo shop Amazon.it con Disponibilità immediata. Disponibile consegna express con Amazon Prime. giorni lavorativi.
Prodotti simili
29,66 €
Amazon.it
Spedizione gratuita

Análise económica dos contratos: Uma abordagem interdisciplinar do direito dos contratos em diferentes sistemas jurídicos
60,90 €
Amazon.it
Spedizione gratuita
Non dimenticarti del tuo codice sconto:
Segnala violazione
State per segnalare una violazione legale sulla base della Legge sui servizi digitali dell'UE.